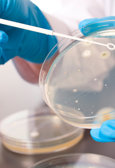
Infection management AMR and sepsis

Medical Care – driving change is a collaborative resource hub to support clinicians and their teams to develop and deliver sustainable improvement, launching on 30 March at Medicine 2023 and online.
Our central themes include educating, improving, and influencing healthcare outcomes by connecting various groups:
If you'd like to get involved, please complete this form and we'll be in touch.
Sign up for our monthly newsletter and to receive occassional updates.
Providing care to ‘outpatients’ is central to specialty medicine and the RCP has a key role in the development and improvement of these services. The RCP is setting out new ambitions for outpatient care and the actions we need to take to deliver real change.
Resources based on the four evidence based interventions recommended by the RCP.
3 new resources have been launched by the Parkinson’s Excellence Network to support hospitals to improve the delivery of medication for people with Parkinson’s:
Spotlight November 2023 explores how healthcare supports climate action, featuring sustainable practices, low-carbon care, and net-zero solutions in line with COP28.
Spotlight October 2023 looks at progress that has been made on the NHS Long Term Plan for respiratory health, including resources on NRAP, lung health checks and pulmonary rehabilitation.
Spotlight September 2023 covers health disparities, changes in respiratory care, and information on social determinant and equity approaches.
Spotlight August 2023 covers virtual wards and hospital-at-home systems using webinars, professional opinions, and sustainable care plans to improve patient results.
Spotlight July 2023 focuses on digital transformation in healthcare, featuring resources on digital health systems, reducing staff pressures, and improving patient care.
June 2023 under the spotlight stresses patient safety, offering webinars on the Patient Safety Incident Response Framework (PSIRF), techniques for enhancing hospital discharge medicine safety, and blogs on cultural shifts in patient safety and Clean Air Day activities.
Spotlight May 2023 covers health coaching and co-production, featuring blogs on self-compassion, videos introducing Dr. Aicha Bouraoui, and webinars on integrating health coaching.
April 2023 spotlight highlights sustainability in healthcare and offers videos on sustainable activities and climate action as well as blogs examining the health consequences of climate change.
Our spotlight for November 2024 focuses on artificial intelligence. See below for the resources.
Discover our key topics for January 2025. These topics and themes will be prevalent throughout the year.
Spotlight - April 2025: Health inequalities Focusing on health inequalities topics for April 2025
Welcome to Medical Care - driving changes book club. A space for thought-provoking discussions with brilliant minds and inspiring authors
The Royal College of Physicians is delighted to relaunch its Excellence in Patient Care Awards! The awards will recognise and celebrate the ground-breaking work of our members and fellows globally to improve patient care through education, policy, clinical practice and research. Following a short break due to the COVID-19 pandemic, we believe that it is now more important than ever to acknowledge and showcase the innovative work taking place in the healthcare community. There is still much to celebrate against the backdrop of current challenges and pressures faced by the NHS.
If you would you like to share work or a project that has made a significant impact for your patients and teams, and provide colleagues with an opportunity to learn and innovate, submit your entry below!
Explore the finalists of the Excellence in Patient Care Awards 2025, celebrating innovation, compassion, and impact across global healthcare practice.
Hear from the 2025 Excellence in Patient Care Award winners as they share their stories, innovations, and impact on patient care. More coming soon.
This guide has been created from a combination of expert opinion, review of the literature and the author’s and contributors’ own experiences.